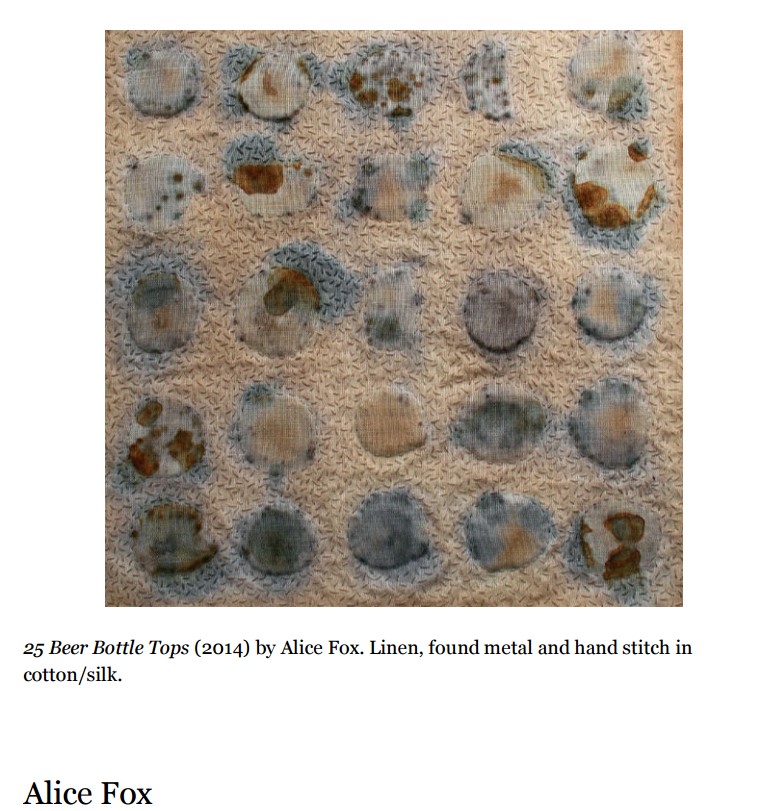

C7Ę■čbįO(sh©©)ėŗ╩ų╣ż├µ┴Ž╝Ī└Ēį┘įņ┤╠└C║═╝Å┐Ś╦ćąg(sh©┤)TextileArtĖ▀ŪÕ╦ž▓─

-
- ār Ė±Ż║ Żż 12
- Į±╚šārĖ±Ż║ ėą╠žāršł┬ō(li©ón)ŽĄ
- ╔╠ŲĘÄņ┤µŻ║ 61 ╝■
- ŲĘ┼ŲŻ║
- žø╠¢Ż║5dd5c18c6caa
- ┴ó┐╠┬ō(li©ón)ŽĄ┘Å┘I┬ō(li©ón)ŽĄ╔╠╝ę
- ▒ŠĄĻ 24 hours śO╦┘░l(f©Ī)žøŠW(w©Żng)▒Pµ£Įė / ▀z╩¦ča(b©│)░l(f©Ī)
╬─╝■ā╚(n©©i)╚▌Ż║Ę■čbįO(sh©©)ėŗ╩ų╣ż├µ┴Ž╝Ī└Ēį┘įņ┤╠└C║═╝Å┐Ś╦ćąg(sh©┤)Textile ArtĖ▀ŪÕ╦ž▓─
╬─╝■Ė±╩ĮŻ║Ė▀ŪÕPDF
╬─╝■ĒōöĄ(sh©┤)Ż║189Ēōū¾ėę
╬─╝■Ž±╦žŻ║Ė▀ŪÕ
╬─╝■┐é┤¾ąĪŻ║12MBū¾ėę
- ó▌Ęų║├įuŠ═┘ø╦═Š½ą─╩š╝»Ą─┘Y┴ŽŻ¼░³└©—╩ź±RČĪĘ■čbįO(sh©©)ėŗĪó╦ćąg(sh©┤)įO(sh©©)ėŗū„ŲĘĄ╚╦ž▓─
- ĻP(gu©Īn)ė┌░l(f©Ī)žø Ż║ĖČ┐Ņ║¾╬ęéāĢ■┴ó╝┤░l(f©Ī)╦═░┘Č╚ŠW(w©Żng)▒Pµ£ĮėŻ¼╚ń╣¹ėHąĶę¬░č╬─╝■ų▒Įė░l(f©Ī)Ó]ŽõŻ¼šłÓ]╝■ų▒ĮėĖµįV╬ęÓ]ŽõĄžųĘŻ¼ę╗░ŃĢ■┴ó╝┤░l(f©Ī)üĒŻ¼╗“├┐═Ē20³cū¾ėę░l(f©Ī)╦═Įo─·Ż╗╬─╝■ėąą®╩Ūē║┐s░³Ż¼ąĶę¬ĮŌē║Ą─Ż╗ėąę╔å¢ļSĢr┐═Ę■Ż¼ę╗░ŃČ╝į┌ŠĆĄ─ĪŻ
——————— ā╚(n©©i)╚▌š╣╩Š ———————

- ĻP(gu©Īn)ė┌╩šžø╝░Ž┬▌d Ż║╬ęéāę╗░Ń╩Ū░l(f©Ī)░┘Č╚ŠW(w©Żng)▒Pµ£ĮėÓ▐Ż¼┤“ķ_░l(f©Ī)üĒĄ─µ£Įė╚╗║¾▌ö╚ļ├▄┤aŻ¼³cō¶Ųš═©Ž┬▌d╝┤┐╔Ż╗Į©ūh▒Ż┤µĄĮūį╝║Ą─░┘Č╚ŠW(w©Żng)▒PŻ¼╩Ū║▄ķLĢrķg▒Ż┤µ▓╗üG╩¦Ą─ĪŻ
1.╬─╝■▌^┤¾Ą─Ż¼Ž╚▒Ż┤µĄĮūį╝║ŠW(w©Żng)▒PŻ¼╚╗║¾╚ź┐═æ¶Č╦Ž┬▌dŻ╗
2.╚ń╣¹╩ŪŽ┬▌d┘Y┴ŽŻ¼ąĶę¬ėąī”æ¬(y©®ng)Ą─▄ø╝■ų¦│ųŻ¼╚ńPDFķåūxŲ„Īóē║┐s░³ąĶę¬ėąĮŌē║▄ø╝■Ą╚Ż╗
- ę“×ķļŖūė╦ž▓─┐╔Å═(f©┤)ųŲŻ¼┤╦ŅÉ╩Ū▓╗═╦žøĪó▓╗ōQžøĪó▓╗═╦┐ŅĄ─ĪŻ
-
ūŅĮ³õN╩█:ęč╩█│÷22 šŲ╣±:─ŪĢrĄ─Š«╦«×│Żż18 į¬
-
ūŅĮ³õN╩█:ęč╩█│÷21 šŲ╣±:─ŪĢrĄ─Š«╦«×│Żż12 į¬




 šŃ╣½ŠW(w©Żng)░▓éõ 33011002014641╠¢
šŃ╣½ŠW(w©Żng)░▓éõ 33011002014641╠¢